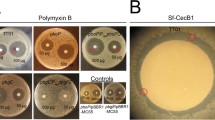

Abstract
Photorhabdus asymbiotica is a species of bacterium that is pathogenic to humans whilst retaining the ability to infect insect hosts. Currently, there are two recognised subspecies, P. asymbiotica subsp. asymbiotica and P. asymbiotica subsp. australis with strains isolated from various locations in the USA, Australia, Thailand, Nepal and Europe. Like other species of Photorhabdus, P. asymbiotica subsp. australis was shown to form a symbiotic relationship with a Heterorhabditis nematode. In contrast to most strains of Photorhabdus luminescens, P. asymbiotica can grow at 37 °C and this is a defining factor in its ability to cause human disease. Insights into other adaptations it has undergone that have enabled host switching to occur have come from whole genome sequencing and transcriptomic studies. P. asymbiotica has a smaller genome compared to P. luminenscens with a lower diversity of insecticidal toxins. However, it has acquired plasmids and several pathogenicity islands in its genome. These encode genes with similarity to effectors or systems found in other known human pathogens such as Salmonella and Yersinia and are therefore likely to contribute to human pathogenicity. Of crucial importance to virulence is the fact that P. asymbiotica undergoes a large metabolic shift at the human host temperature.
Access provided by CONRICYT-eBooks. Download chapter PDF
Similar content being viewed by others
Keywords
These keywords were added by machine and not by the authors. This process is experimental and the keywords may be updated as the learning algorithm improves.
1 Introduction
Photorhabdus asymbiotica was originally described in 1989 after being isolated from a patient with a leg ulcer in the USA. This was followed by a search of the records of the Centres for Disease Control and Prevention that revealed three more previously reported cases (Farmer et al. 1989). There are 15 cases reported in the literature and they involve soft tissue infections that are often multifocal, whilst in five cases there was also an associated bacteraemia (see also the current review of clinical cases by John Gerrard in this volume). All of the reported cases occurred in North America and Australia and were generally associated with outdoor activities in warm weather conditions (Gerrard et al. 2004). The existence of additional isolates from Thailand and Nepal (Gerrard et al. 2011; Thanwisai et al. 2012) indicates a widespread geographical distribution of the species. However, epidemiological information on P. asymbiotica is likely to be incomplete since infections are probably misdiagnosed, as commonly used automated bacterial identification systems misidentify this pathogen (Gerrard et al. 2003). The fact that the majority of cases reported originate from neighbouring locations may therefore simply reflect the increased awareness of clinicians in those areas regarding the possibility of infection with this unexpected pathogen (Weissfeld et al. 2005). Alternatively, it could point to the existence of specific localised pools of closely related strains, or their symbiont nematodes, that have acquired adaptations enabling them to infect human hosts. So far there are two recognised subspecies of P. asymbiotica, P. asymbiotica subsp. asymbiotica, found in the USA and P. asymbiotica subsp. australis, which includes the Australian isolates (Gerrard et al. 2006; Peat et al. 2010) and the isolate from Thailand (Thanwisai et al. 2012).
Since the bacteria were first identified from clinical isolates, it was originally believed they did not form the normal symbiotic relationship with the nematode vector. They were therefore originally described as being ‘a-symbiotic’ as the species name suggests. Eventually however, a nematode belonging to the genus Heterorhabditis was found to be associated with the clinical P. asymbiotica Kingscliff isolate from Australia (Gerrard et al. 2006). The nematode is most closely related to H. indica, but is classified as a distinct species, H. gerrardi (Plichta et al. 2009). In addition, certain bacterial strains isolated from soil isolates of Japanese Heterhorhabditis nematodes are phylogenetically most related to P. asymbiotica species (Kuwata et al. 2008). It should be pointed out, however, that Heterhorhabditid nematodes vectoring any North American isolates have not yet been identified.
Nevertheless, Photorhabdus species have never been found to occur free-living in the soil, even though at least some can grow in soil under laboratory conditions (Bleakley and Chen 1999). The mechanism of transmission to humans also remains unknown. In the case of infection with P. asymbiotica strain Kingscliff a preexisting skin injury was reported (Gerrard et al. 2006). However, in other incidences there was no known prior skin lesion (Gerrard et al. 2011). The most likely hypothesis is that the nematode vector penetrates human skin and delivers the Photorhabdus subcutaneously enabling establishment of the infection. Interestingly, it remains a formal, but unproven, possibility that as yet unrecognised mammalian or bird species could provide natural hosts for these particular strains and their associated nematodes.
Importantly, all North American and Australian P. asymbiotica isolates tested have the ability to grow at temperatures of 37 °C or above. Interestingly, the strains isolated from Australia are able to tolerate even higher temperatures than those isolated from North America. Amongst all the P. asymbiotica genospecies so far examined, the only strains not able to grow at temperatures over 34 °C are two strains isolated from Northern Europe (P. asymbiotica strain HIT and P. asymbiotica strain JUN) (Mulley et al. 2015). These observations suggest that adaptation of the P. asymbiotica ‘genospecies’ to elevated temperatures may have been influenced by geographical location and climatic conditions. While most strains of P. luminescens tested cannot grow at elevated temperatures there are examples of some that can (Fischer-Le Saux et al. 1999). It is not known if these would be capable of causing human infection given the opportunity. However, as no clinical cases have been ascribed to any member of the genus other than P. asymbiotica, we suggest it implies certain adaptations are required that are not found in the P. luminescens genospecies.
2 Insights from the P. asymbiotica Genome
Genomic data is an invaluable source of information enabling the identification of factors that have allowed host switching to occur. Currently, a complete genome of a USA isolate (ATCC 43949) (Wilkinson et al. 2009) and two draft genomes of Australian isolates, P. asymbiotica Kingscliff (Wilkinson et al. 2010) and P. asymbiotica subsp. australis DSM 17609 (our unpublished data) are available. Comparison between these and the genome sequences of P. luminescens strains has revealed a smaller genome size for P. asymbiotica with a concurrent acquisition of novel elements. The genome of P. asymbiotica ATCC 43949 is 5,064,808 bp (Wilkinson et al. 2009) compared to that of P. luminescens TTO1 at 5,688,987 bp (Duchaud et al. 2003). The P. asymbiotica strains harbour extra-chromosomal elements, with the USA strain carrying one plasmid, pPAU1, which bears some homology to the pMT1 plasmid from Yersinia pestis. The presence of the latter is necessary for Y. pestis to be able to colonise its flea vector. The Australian P. asymbiotica strain also carries a pPAU1 homologue (pPAA1), but in addition also carries a second plasmid element, pPAA3. This bears similarity to pCRY from Yersinia pestis 91001 and encodes a Type IV pilus system, which may be involved in either plasmid conjugation or, alternatively as a Type IV toxin secretion system. No plasmids have yet been identified from either P. luminescens or P. temperata isolates despite an early report of plasmid isolation from P. luminescens MU2 (Bondi et al. 1999). Interestingly our unpublished Illumina whole genome sequencing of the HIT and JUN isolates has confirmed that these strains also contain sequences homologous to the pPAU1 plasmid. In the case of pPAJ from P. asymbiotica strain JUN, we can also confirm that this exists as a closed circle independent of the chromosome. Interestingly in this pPAJ plasmid an alternative origin of replication has inserted into the normal pPAU1 repA gene, although the significance of this, if any, is not known.
Even though the exact function of the P. asymbiotica plasmids has not been determined, our previous attempts to cure pPAU1 failed. Furthermore, P. luminescens TT01 transformed with pPAU1, genetically tagged with an antibiotic resistance marker, becomes non-viable after only two or three subcultures. This suggests there is genetic cross talk between plasmid and chromosome and that the presence of these plasmids is somehow required for normal growth of P. asymbiotica. Furthermore, comparisons of whole genome phylogeny of P. asymbiotica isolates with the whole plasmid sequence phylogeny shows the same tree topology suggesting that acquisition of the pPAU1-like plasmid was ancestral to the speciation of P. asymbiotica within the genus.
Other differences noted between the genomes of P. asymbiotica and P. luminescens are in Type III secretion systems (T3SS). T3SS are used by pathogens to introduce their own protein effectors into host cells. P. luminescens possesses one T3SS with at least one tightly linked effector, LopT that is homologous to the Yersinia pestis YopT. YopT is a serine protease that causes disruption of the host cell cytoskeleton (Shao et al. 2002). As is the case with Yersinia, lopT is found in an operon with slcT, which encodes a putative LopT chaperone, so it is likely that the function of the two proteins in Photorhabdus is similar to that of the Yersinia homologues. Indeed previous work by Brugirard-Ricaud et al. confirmed the role of LopT in preventing phagocytosis of P. luminescens by insect hemocytes (Brugirard-Ricaud et al. 2005). At the corresponding T3SS locus in P. asymbiotica, however, LopT is absent and instead the T3SS operon encodes a homologue of ExoU from Pseudomonas aeruginosa. ExoU is a known phospholipase (Sato et al. 2003) that is the cause of acute lung injury leading to sepsis (Pankhaniya et al. 2004). Additionally, P. asymbiotica appears to have acquired a second T3SS structural operon, related to a system from clinical isolates of Vibrio parahaemolyticus (Park et al. 2004). Moreover, at a separate genomic location, and likely exported by the T3SS, P. asymbiotica also encodes a homologue of sopB. SopB is T3SS effector of Salmonella enterica serovar Typhimurium and is involved in the maturation of the Salmonella-containing vacuole via recruitment of Rab5 (Mallo et al. 2008). Finally, P. asymbiotica contains a homologue of vopS from V. parahaemolyticus, which is another T3SS effector, which modifies small Rho-family GTPases by AMPylation.
Photorhabdus Virulence Cassettes (PVCs) are discrete operons encoding proteins similar to phage tail and Type 6 Secretion System components. They encode macromolecular phage tail-like structures superficially similar to R-type pyocins (Yang et al. 2006). Unlike pyocins however, which target other bacterial cells, the PVCs appear to be used as a mechanism for delivery of Photorhabdus effectors into eukaryotic cells (Yang et al. 2006). Each cassette consists of typically 16 genes that encode the structural components of the PVC ‘needle complex’, followed by one or more genes encoded at the 3′ end of the operon that are homologues of typical T3SS-like toxin effectors. Indeed transient expression of several example effectors in mammalian cells confirmed profound effects of the cell cytoskeleton (Yang et al. 2006). The genome of P. luminescens contains six PVC loci, four of which are arranged in tandem (PVC units 1–4). Different putative effectors are associated with each unique PVC cassette. The genome of P. asymbiotica encodes only five PVCs (Fig. 1). In particular, PVC units 1–3 are absent from the genome and only the apparently ancestral PVCunit4 is conserved in the same syntenic locus. Interestingly this PVCunit4 encodes effectors distinct from those found on the P. luminescens equivalent. The P. asymbiotica PVCunit4 encodes two effectors that are homologous to gogB from Salmonella enterica serovar Typhimurium and Escherichia coli and thus may play a role in the mammalian infection process. In contrast, at the equivalent P. luminescens locus there are two genes related to halovibrin from Vibrio fischeri. Halovibrins are secreted proteins that may facilitate the symbiotic relationship between V. fisheri and the Bobtail squid (Stabb et al. 2001). As such, it is tempting to speculate that this particular PVC locus might be performing a similar symbiosis role between the bacteria and the Heterorhabditis nematode. It should be noted that an analogous, and at least partially homologous, PVC-like ‘injectosome’ needle complex system is employed by the bacterium Pseudoalteromonas luteoviolacea which it uses to control the metamorphosis of the marine worm Hydroides elegans (Shikuma et al. 2014). This suggests that the PVC-like elements may be an ancient and a general mechanism for controlling many aspects of interaction with invertebrate hosts, including their development.
The Photorhabdus virulence cassettes (PVCs). PVCs found in the genome of P. luminescens are shown in (a) and PVCs found in P. asymbiotica 43949 are shown in (b). Dashed lines between (a) and (b) show conserved elements, whilst dotted lines indicate the genomic region of P. luminescens TT01 that is absent from the corresponding locus of the P. asymbiotica 43949 genome. A more detailed schematic representation of the P. asymbiotica PVCpnf operon is shown in (c)
Two more PVC elements, PVClopT and PVCcif are conserved between the two species. However, P. asymbiotica also contains two additional unique PVC elements: PVCPaTox and PVCpnf. The latter is toxic to insects by injection (and their hemocytes) when heterologously expressed from a cosmid clone in E. coli (Yang et al. 2006). The Pnf effector is homologous to the cytotoxic necrotizing factor (CNF1) from E. coli (Fabbri et al. 2010). Interestingly, while a PVC operon is present in the equivalent locus in the genome of the Australian strain P. asymbiotica Kingscliff, a gene coding for an alternative effector has replaced pnf. This highlights the variability and flexibility in these novel delivery systems (Wilkinson et al. 2010). Moreover, the effector of the PVCPaTox element, encoded by gene PAU_02230, has been identified as a P. asymbiotica toxin and is termed PaTox (Jank et al. 2013). PaTox has some similarity to the Salmonella virulence factor SseI. SseI is an effector of the Salmonella pathogenicity island 2 T3SSS that is thought to inhibit migration of immune cells and in particular antigen presenting cells (McLaughlin et al. 2009). The gene encoding PaTox was identified separately following a search in the P. asymbiotica genome for the presence of motifs found in the glycosylating toxins of Clostridium and Legionella (Jank et al. 2013) (see also the Chapter by Andrea Dolwing in this volume).
Another well-known toxin system first discovered in Photorhabdus are ABC-type ‘Toxin Complexes’ encoded by tc genes (see also the Chapter by Klaus Aktories in this volume), some of which are responsible for oral toxicity to insects. The toxins are composed of TcA, TcB and TcC subunits. The TcA subunit contains the host cell receptor binding component and forms a homo-oligomeric injection complex which is used to inject the TcB-TcC subunits into the host cell cytoplasm (Gatsogiannis et al. 2013). Different TcC homologues possess different C-terminal domains and at least one of which has been shown to function as an ADP-ribosyltransferase. The genes encoding these were initially seen to be located on four distinct pathogenicity islands in strain P. luminescens W14, from which the toxins were first identified and purified (Bowen and Ensign 1998). These pathogenicity islands were named, tca, tcb, tcc and tcd. Since genome sequences have become available it is possible to see significant variation in tc toxin gene complement and organisation, even between different P. luminescens strains. For example, in strain TT01 the tca island has undergone deletion of most of tcaA and tcaB and the tcb island has also been mostly deleted. However, a comparison with the P. asymbiotica genome reveals even greater differences in tc gene complement. For example, in addition to an independent tcaAB deletion event, in P. asymbiotica an additional tccC homologue is encoded on the tca island. Furthermore, the tcd island is much reduced with four of the equivalent P. luminescens genes missing (Wilkinson et al. 2009). These differences are observed in both the American and the Australian sequenced P. asymbiotica isolates (Wilkinson et al. 2010). Indeed comparative genomics suggests that the P. asymbiotica tcd island is likely to represent a smaller more ancestral state and that the P. luminescens strains have acquired additional homologues.
The genome of P. asymbiotica also shows a reduced complement of other toxin homologues compared to P. luminescens. For example, while P. luminescens possesses two homologues of the large Makes Caterpillars Floppy toxin (mcf1 and mcf2), P. asymbiotica only carries the mcf1 homologue. Mcf1 possesses a BH3-like N-terminal domain which induces apoptosis in hemocytes and the insect midgut epithelium (Daborn et al. 2002). Mcf2 on the other hand, has an N-terminal domain that shows similarity to HrmA (Waterfield et al. 2003), a T3SS effector of Pseudomonas syringae. Transfection of this N-terminal domain into mammalian NIH3T3 cells resulted in cell death (Waterfield et al. 2003). Expression of either Mcf1 or Mcf2 confers virulence properties to E. coli and enables the bacteria to kill insects (Daborn et al. 2002; Waterfield et al. 2003). An additional example can be found with the pirAB toxin genes. Unlike P. luminescens, which has two loci encoding PirAB toxins, P. asymbiotica only encodes one such locus, equivalent to the plu4093-plu4092 genes of TT01. The PirAB toxins have strong insecticidal activity against Diptera and Lepidoptera (Waterfield et al. 2005; Ahantarig et al. 2009). A crystal structure of the Vibrio parahaemolyticus PirA and PirB homologues has revealed similar topology to the Bacillus pore-forming Cry toxin, suggesting a similar mode of action (Lee et al. 2015). Finally, P. asymbiotica 43949 is missing four haemolysin-encoding loci, which are present in P. luminescens. It must be noted, however, that a comparison between the genomes of the Australian P. asymbiotica Kingscliff isolate and P. asymbiotica 43949 does reveal that the former contains several haemolysin or haemagglutinin genes that are not found in the USA isolate (Wilkinson et al. 2010). Whether these are employed during the infection in the insect or in the mammalian infection process is still unknown.
The differences discussed above in the toxin compliments of P. asymbiotica 43949 and P. luminescens TT01 are illustrated in a functional genomics comparison between the two species. This follows the results of a screen whereby parts of the two genomes were cloned into cosmids and introduced into E. coli. The resulting E. coli clones were then tested for toxicity against insects, macrophages, amoebas or nematodes (Waterfield et al. 2008). As can be seen in Fig. 2, a comparison of the genetic regions of the two bacteria, which are capable of conferring toxicity, shows that a number of toxins found in P. luminescens TT01 are absent from P. asymbiotica 43949, whilst the latter has acquired novel elements. Additionally, there are parts of the genome that are conserved between the two species that do not seem to encode toxic products in P. luminenscens, but do so in P. asymbiotica. This may reflect specific adaptations in P. asymbiotica that facilitate infection of the human host.
A comparison of the rapid virulence annotation (RVA) functional genomics screens of P. asymbiotica 43949 and P. luminescens TT01. The image represents an artemis comparison tool alignment of the two genomes. Boxes above and below the genomes represent regions of the genome containing genes that elaborate toxic products in E. coli cosmid clones. RVA gain of toxicity screens were performed against Manduca sexta insects (i), Mammalian macrophages (m), Acanthamoeba polyphaga amoeba (a) and C. elegans nematodes (n). The RVA numbers at the top refer to the relevant regions presented in the supplementary data in (Waterfield et al. 2008), where the P. asymbiotica RVA screen was described. The P. luminescens RVA data is unpublished
Genetic differences between P. asymbiotica and the other species of the genus involving genes that encode non-toxin products may also be of significance to its life style and its ability to infect humans. One such example is the LPS biosynthesis locus whereby there is a large region that is different between P. asymbiotica 43949 and P. luminescens TT01. In particular, a 17 kb region of P. luminescens TT01 has been replaced by a region of 18 kb that contains putative O-antigen synthesis genes. Elucidation of the structure of the O-polysaccharide of various P. asymbiotica strains has revealed that there are some subtle differences between Australian and American isolates since there are higher levels of O-acetylation in the American strains. However, in general the structure resembles those of other important phylogenetically distant pathogens, such as Francisella tularensis or Shigella dysenteriae type 7 (Kondakova et al. 2011). Thus, the differences observed between P. asymbiotica and P. luminescens in this respect may reflect an additional adaptation of the former to its new host.
3 P. asymbiotica as an Insect Pathogen
Despite the overall lower diversity of insecticidal toxin genes in the P. asymbiotica genome, the ability of the bacterium to infect model insects is unaffected. Indeed, P. asymbiotica is more pathogenic against model insect hosts than the other members of the genus. Eleftherianos and coworkers observed that using a dose of approximately 100 bacteria to infect Manduca sexta larvae, the LT50 of P. asymbiotica 43949 is 30 h, whilst that of P. luminescens is 56 h (Eleftherianos et al. 2006). Nevertheless, it cannot be ruled out that as a result of the lower diversity of toxin genes in P. asymbiotica the bacterium is unable to infect as large a range of insect host species as P. luminescens. To our knowledge, the virulence of P. asymbiotica against a range of insect hosts has not been tested.
Interestingly, P. asymbiotica becomes unable to cause a successful infection in Manduca sexta larvae when the infected insects are incubated at 37 °C (Mulley et al. 2015). This suggests that the bacteria are not naturally found in an insect host at this temperature and that they have adapted other mechanisms that are better suited for an infection of mammalian hosts. The apparent increased virulence of P. asymbiotica at the lower temperature of 28 °C could be a result of the presence of additional virulence factors that the species has acquired. For example, the PaTox is not found in other Photorhabdus species and could contribute to virulence against insects. The toxin consists of a deamidase and a glycosyltransferase domain. The activity of the deamidase domain constitutively activates heterotrimeric G proteins, whilst the glycosyltranferase domain modifies small Rho-family GTPases in their GTP-bound active state. Overall, PaTox activity results in actin cytoskeleton disassembly and thus inhibition of phagocytosis. Pa Tox is active against both insect cells and mammalian cells (Jank et al. 2013). Similarly, the PVCpnf that is specific to P. asymbiotica is another potent insect virulence factor. Injection of recombinant PVCpnf into Galleria melonella larvae is lethal and hemocytes recovered from the larvae show severe actin cytoskeleton rearrangement (Yang et al. 2006).
It is important to note here that P. asymbiotica can be found within insect hemocytes, unlike P. luminescens which remains extracellular (Brugirard-Ricaud et al. 2005; Costa et al. 2009; Vlisidou et al. 2010). The rate of uptake of P. asymbiotica by hemocytes appears to depend on the subspecies, since Australian isolates seem to be taken up more readily than USA isolates (Wilkinson et al. 2009; Costa et al. 2009). The ability of P. asymbiotica to survive in cells means that the pathogen may have alternative uses for factors that are present across the genus. For example, the KdpD/KdpE two component system of P. asymbiotica contributes to survival of the bacteria within insect hemocytes (Vlisidou et al. 2010). Vlisidou and coworkers showed that it alone could enable nonpathogenic E. coli to resist phagocytic killing by increasing expression of the native high affinity potassium pump Kdp (Vlisidou et al. 2010). How exactly this interferes with the hemocyte ability to kill the phagocytosed bacteria is not clear, but E. coli was able to persist long enough to result in the death of injected Manduca sexta larvae (Vlisidou et al. 2010). A KdpD/KdpE system is also present in P. luminescens but it is not clear whether this would provide an advantage to the bacteria during the infection if they are not found within host cells. Moreover, the ability of P. asymbiotica to enter and survive within the host cells implies that toxin molecules synthesised by the bacteria might become released directly into the host cell cytosol without the need for a delivery mechanism. This could allow for example the P. asymbiotica Tca BC to act as a functional toxin despite the lack of the pore-forming TcA subunit, as there is no need for transport of the toxin across the host cell membrane. On the other hand, even though P. asymbiotica virulence against model insect hosts appears to be undiminished, oral toxicity of the bacteria is attenuated due to the lack of certain tc genes, required for full oral toxicity.
4 The Human Host
4.1 Overcoming Host Defences
Many of the immune-defence strategies that Photorhabdus must overcome in an insect have parallels in a human host. In fact many aspects of innate immunity at both a mechanistic and even genetic level are conserved between many invertebrates studied and humans (Browne et al. 2013; Buchmann 2014; Kimbrell and Beutler 2001). These could be either part of the humoral response, such as the presence of antimicrobial peptides and production of lysozyme, or the cellular innate immune response, which involves phagocytic attack by hemocytes in the insect or macrophages in the human host. Thus, it may be envisaged that the mechanisms employed by the bacteria to evade the response of the insect can be adapted to address these similar issues encountered in the human host. In support of this notion, it was recently demonstrated that both P. luminescens and P. asymbiotica can survive and grow in the presence of human serum (Mulley et al. 2015). This suggests that the adaptations that allow Photorhabdus to overcome killing by components of the insect serum, provide sufficient protection against human serum. Importantly though, unlike P. luminescens, P. asymbiotica is also able to survive in the presence of both pig and rabbit serum. Similarly, the aglycon precursor of rhabducin, a known inhibitor of the insect phenol oxidase cascade (Crawford et al. 2012) was also shown to inhibit the human alternative complement pathway (Mulley et al. 2015). Additionally, RNAseq analysis of P. asymbiotica revealed the up-regulation of isnAB transcription for the synthesis genes of rhabducin at 37 °C, compared to at 28 °C (Mulley et al. 2015). Even though there was no detectable increased secretion of free rhabducin itself (Mulley et al. 2015), most of the molecule is normally found on the cell surface (Crawford et al. 2012). Another Photorhabdus secondary metabolite whose levels actually increase at 37 °C and thus may be relevant in the human infection process is iso-propyl-stilbene (IPS). IPS is produced by both P. luminescens and P. asymbiotica and is an antibiotic compound with multiple other activities that is also required for symbiosis (Joyce et al. 2008; Li et al. 1995) (see also the Chapters by David Clarke and Helge Bode on secondary metabolism also in this volume). Interestingly, IPS also seems to have immunomodulatory properties (Zang et al. 2016) so it could be another example of a factor present in the Photorhabdus genome that is being repurposed by P. asymbiotica during a human infection. Finally, the secreted metalloprotease PrtA, which is found in both clinical and nonclinical strains of Photorhabdus might be involved in defence against the immune system in the human host. This is supported by the identification of several PrtA-sensitive proteins with immune related function, following exposure of insect haemolymph to PrtA digestion in vitro (Felföldi et al. 2009). It remains to be confirmed whether these proteins are PrtA targets in vivo.
Bacterial pathogens can either remain outside host cells or survive and replicate inside them. Furthermore, some that are facultative intracellular pathogens can switch between both strategies. Experiments in vitro using both murine and human macrophage-like cells have shown the P. asymbiotica can enter these phagocytic cells (Wilkinson et al. 2009; Costa et al. 2009). Costa et al. (2009), observed that P. asymbiotica could actually survive and replicate inside human macrophage-like THP-1 cells. It is tempting to speculate that the ability to survive intracellularly is at least in part mediated by the P. asymbiotica SopB homologue discussed previously. Additionally, Australian but not American isolates are able to invade the non-phagocytic HeLa cells (Costa et al. 2009). It is possible that the increased ability of the Australian isolates to invade host cells is due to the presence of the Type 4 secretion system encoded by the second plasmid (pPAA3) found in these strains. This may enable the bacteria to gain access to specific sites in the host thus allowing for a more disseminated infection to take place. Indeed, we may contemplate that the bacteraemic dissemination of P. asymbiotica around the bodies of patients with Photorhabdosis is facilitated by the invasion of macrophage, neutrophils or other circulating white blood cells. Invasion into host cells can not only provide a niche sheltered from certain aspects of immunity, but can also grant access to certain nutrients, promoting persistence in the host.
Similarly to insect cells, following infection with P. asymbiotica, mammalian macrophage-like cell lines, as well as primary human macrophages later show signs of apoptosis. The effect is more pronounced with the Australian isolates as infection with the American isolates results in apoptosis being detected much later and at a lower rate. This appears to be specific to macrophage-like cells, as after infection of HeLa no signs of programmed cell death were observed (Costa et al. 2009). Apoptosis induction occurs after addition of bacteria to cells but does not require uptake of the pathogen. Additionally, it can be triggered by the addition of bacterial culture supernatant in the absence of bacteria. This indicates that the virulence factor responsible for host cell apoptosis is secreted. The identity of this virulence factor remains elusive and it is possible that there are multiple molecules exerting these effects, but one likely candidate is Mcf1. Even though Mcf1 was previously shown to cause apoptosis in HeLa cells (Dowling et al. 2004), which was not observed with P. asymbiotica, mcf1 becomes up-regulated when the bacteria are grown at 37 °C, compared to expression at the normal growth temperature of 28 °C (Mulley et al. 2015). More clues come from the findings of a recent study performed with E. coli clones carrying cosmids that contain different regions of the P. asymbiotica genome (Dowling and Hodgson 2014). The effect of administration of E. coli lysates on macrophages was closely monitored. Here, a synergistic effect was observed between Mcf1 and the product of a nonribosomal peptide synthase (NRPS) cluster (PAU03356-PAU03357) located upstream of mcf1. Whilst administration of Mcf1 alone resulted in condensation of the cytoskeleton, co-administration with the NRPS product led to the formation of cytoskeletal protrusions and actin ruffles (Dowling and Hodgson 2014). This indicates that such NRPS secondary metabolites may also play a role in pathogenicity of P. asymbiotica as is known for several other bacterial species.
The transcription of certain other putative virulence factors of P. asymbiotica was shown to be up-regulated at 37 °C. These include, PVCunit4 and its associated effectors, insect toxin pirB, an operon containing a putative invasin (PAU_02531-37) and a sepC toxin-like gene (PAU_0214) (Mulley et al. 2015). On the contrary, the gene encoding the insect toxin XaxA is one of the few virulence genes that are down-regulated at 37 °C. This suggests that this factor may be specific for insect cells or would otherwise cause a problem in a human infection. Finally, the expression of the second T3SS and its effectors appears to be unaffected, however it is likely that direct contact with host cells might be a requirement for up-regulation. It should be noted that the published RNAseq work looked at changes in gene transcription in relation to temperature alone.
4.2 Metabolic Adaptations
The nutrients available in the human host niche are likely to be distinct from those in the insect host. Therefore, in addition to the deployment of toxins and other immune effector defence mechanisms, pathogens must be able to adjust their metabolism to ensure optimal nutrient acquisition and assimilation. Temperature can be sensed by many bacteria, and used as a signal to determine entry into a mammalian host. The bacteria can then respond accordingly, changing the expression of not only virulence but also metabolic genes. To measure these responses a set of transcriptomic, metabolomic and proteomic assays were performed with P. asymbiotica grown at the environmental temperature of 28 °C or the mammalian host temperature of 37 °C (Mulley et al. 2015). These experiments revealed that the metabolic abilities of P. asymbiotica undergo a large shift when grown at the elevated temperature. For example, genes encoding products involved in carbohydrate uptake and metabolism are down-regulated at 37 °C. The decrease in transcript levels of genes in these pathways is in accordance with a reduction of protein levels and the ability to metabolise these compounds in culture. Overall, P. asymbiotica becomes restricted in the substrates it can use as a source of carbon at 37 °C and this could reflect their availability, or lack thereof, in the new host. Examples of carbon sources it can still utilise at 37 °C are glycyl-l-proline, a product of collagen degradation and hence possibly readily available in mammals and N-acetyl-d-glucosamine, a component of connective tissue in both mammals and insects. On the other hand P. asymbiotica can use l-serine as a carbon source at both temperatures, whilst it relies on only a few amino acids and peptides to provide a source of nitrogen at 37 °C. In accordance with this, several genes encoding peptidases and amino acid and peptide transporters become up-regulated at 37 °C. This suggests that the bacteria may rely on the degradation of host proteins and the uptake of peptides and amino acids to be used as nutrient sources in the human. Again, the secreted metalloprotease PrtA might play a role in this. The gene encoding PrtA becomes highly up-regulated at 37 °C and it has been previously suggested that the function of the protease is to support nutrient acquisition even in the insect infection since its levels rise late in the infection process (Silva et al. 2002; Daborn et al. 2001). It is tempting to speculate that a requirement for degrading host proteins at 37 °C might lead to the clinical symptoms of tissue necrosis and ulceration seen in P. asymbiotica infection.
Furthermore, it has been suggested that depleting certain nutrients, such as specific amino acids, from the host can have adverse effects on host cell homeostasis or immune function. This phenomenon has been coined ‘nutritional virulence’ and several examples have been seen in well-studied human pathogens (Abu Kwaik and Bumann 2013). For example, reduction in host cell serine levels would deprive host cells of a source for NADPH generation (Fan et al. 2014), whilst depletion of glutamine, which is required for immune cell function, is known to dampen immune responses (Calder and Yaqoob 1999). Glutamine is used as a source of energy by fast dividing cells such as lymphocytes and is also needed for the synthesis of other amino acids and nucleotides. Additionally, it is required for the synthesis of glutathione, which is important for protection against reactive oxygen species. Many of these pathways are connected to the conversion of glutamine into glutamate (Newsholme et al. 2003). Glutamine deprivation would therefore be detrimental to immune cells not only because it would signify a loss of energy source, but also because of lowered resistance to oxidative damage. This phenomenon has been observed in Helicobacter pylori, which converts both extracellular glutamine and glutathione into glutamate that it then takes up and uses mainly as an energy source (Shibayama et al. 2007). This seems to be a major contributing factor to the pathology of the bacterium (De Bruyne et al. 2016). Glutamine and glutamate are, together with tyrosine, the only amino acids P. asymbiotica can use as a nitrogen source at 37 °C (Mulley et al. 2015). It is therefore possible that the P. asymbiotica metabolism might result in glutamine depletion in host cells and have similar associated effects.
Additionally, P. asymbiotica is able to use purines as carbon sources and xanthine as a nitrogen source at 37 °C, whilst at the same time it down-regulates the de novo purine biosynthesis pathway. This suggests that purines are either abundant or readily available in the host and this could be particularly relevant in an intracellular setting. Indeed some pathogens like H. pylori, Chlamydia trachomatis or Ricketsia prowazekii, which lack either parts of or the entire purine biosynthesis pathway, need to take up nucleotides from the host (Audia and Winkler 2006; Liechti and Goldberg 2012; Tjaden et al. 1999). Additionally, xanthine depletion may also be interfering with the host immune response as xanthine is a substrate of xanthine oxidoreductase (XO) whereby it is converted into uric acid with the associated release of hydrogen peroxide (Crane et al. 2013; Martin et al. 2004). Moreover, in hypoxic conditions XO can use xanthine as a reducing agent to generate nitric oxide (Godber et al. 2000). Thus, the ability of Photorhabdus to utilise xanthine as a carbon source may not only be providing the bacteria with necessary nutrients, but also acting as yet another defence strategy against the immune system.
Iron restriction is used by many animal hosts as an immune-defence strategy to limit the growth of microorganisms (Ganz and Nemeth 2015; Schaible and Kaufmann 2004). Thus, bacterial pathogens often have mechanisms to overcome this restriction (Schaible and Kaufmann 2004; Fischbach et al. 2006). In accordance with this, P. asymbiotica up-regulates the iron compound ABC transporter (PAU_03286), the outer membrane siderophore receptor CjrC and a bacterioferritin co-migratory protein Bcp (Mulley et al. 2015). Interestingly, the strategies employed by the human body to limit iron availability to bacteria will have different effects depending on whether the pathogens are extracellular or intracellular. So, while the sequestration of ferric ions or siderophore-bound iron will limit its availability to most pathogens, inhibition of iron release into the plasma via the degradation of ferroportin leads to a rise in its concentration inside cells like macrophages. This could lead to increased iron availability for pathogens that can survive inside these cells and so additional strategies are required to ensure that iron is excluded from intracellular sites where microbes reside, such as phagosomes (Ganz and Nemeth 2015; Schaible and Kaufmann 2004). Thus, the ability of P. asymbiotica to act as a facultative intracellular pathogen may be enabling it to overcome yet another human defence mechanism.
5 Conclusions
The shift of P. asymbiotica to a new host seems to have been facilitated by three general mechanisms. The first involves making use of virulence mechanisms already present and which are used by all Photorhabdus species when they infect an insect host. These could be toxins or molecules that provide defence against the host immune system. The second mechanism involves the acquisition of additional virulence factors that are appropriate for the mammalian host infection strategy. For example, specific ‘toxin’ effectors, which exert their actions inside host cells, like ExoU or PaTox. It can be envisaged, however, that without the aforementioned preexisting adaptations the newly acquired virulence factors would not be sufficient to confer full pathogenicity to the bacteria. Finally, P. asymbiotica appears to be able to adapt its metabolism to best utilise the new niche. It is possible that the changes that are observed in its metabolism upon shift to 37 °C do not exactly reflect what occurs when the bacteria are found in a human host as additional signals might be present during an infection. Even so, similar experiments with other pathogens have shown a good correlation between such in vitro data and transcriptomic data from infected cells (Bent et al. 2015; Ren and Prescott 2003). Moreover, temperature has been shown to increase expression of known virulence genes in a variety of pathogens (Konkel and Tilly 2000), sometimes controlling translation directly by altering the structure of messenger RNA molecules (Guijarro et al. 2015). Whether the metabolic shift seen with P. asymbiotica 37 °C is simply a result of differential availability of nutrients in the new environment, poor adaptation of certain bacterial enzymes and pathways or rather a specific strategy to use nutritional virulence to simultaneously manipulate the host, is an interesting question to consider. Finally, the inability of P. asymbiotica to infect insects at 37 °C despite an up-regulation of virulence genes, suggests that the changes it undergoes at this elevated temperature constitute specific adaptations to the mammalian host. We argue this failure is most likely due to the large restriction in metabolic abilities.
An analysis of P. asymbiotica genome sequences, in addition to temperature dependant differential transcriptomic, proteomic and metabolic studies have shed light on the characteristics that allow the members of the species to infect humans. Nevertheless, several important questions regarding their adaption to human pathogenicity remain unanswered. One obvious question that arises from comparison of the P. asymbiotica genome with that of the other Photorhabdus species is the role of the plasmid observed in P. asymbiotica. The fact that the European isolates HIT and JUN are unable to grow at elevated temperatures and also seem to contain a pPAU1-like plasmid, but in much lower copy numbers, and at least in one case with an altered origin of replication, hints at a role in the transition to human pathogenicity. Nevertheless, transcriptomics has not shown any significant difference in pPAU1 plasmid gene expression levels between 28 and 37 °C (Mulley et al. 2015), though the possibility that additional signals are required for gene up-regulation cannot be overlooked. One hypothesis for its function is that the plasmid may be introducing an additional level of transcriptional control over chromosomal genes. Such crosstalk between chromosome and plasmid has been observed in some other bacterial pathogens (Chitlaru et al. 2006; Zhu et al. 2010; Letek et al. 2010). This may allow better integration of the horizontally acquired genes enabling utilisation of a new niche. Furthermore, if such regulatory rewiring has occurred, it could explain why the P. asymbiotica ATCC43949 pPAU1 plasmid could not be cured even in laboratory conditions.
Other important questions involve the mode of transmission to humans and the presence, if any, of a mammalian host reservoir. The working hypothesis is that the nematode vector may penetrate human skin and release the bacteria; however, this has not been demonstrated so far. Certain nematodes such Strongyloides stercoralis or the hookworm Ancylostoma duodenale are known to possess this ability (Hotez et al. 2004), but this is not thought to be the case for Heterorhabditis. We have, however, observed that Heterorabditis nematodes can penetrate rat dermis ex vivo (unpublished results). Since human body temperature does not allow Heterorhabditis to survive (Sunanda 2009), such an infection would result in a dead-end for the nematode. Even so, the temperature on the surface of human skin at the extremities is well below 37 °C and this could allow introduction of the bacteria by the nematode. Finally, the possibility that a mammal with a lower body temperature, such as a marsupial, or poikilothermic animals like reptiles act as the reservoir for P. asymbiotica cannot be excluded.
References
Abu Kwaik Y, Bumann D (2013) Microbial quest for food in vivo: “Nutritional virulence” as an emerging paradigm. Cell Microbiol 15:882–890. doi:10.1111/cmi.12138
Ahantarig A, Chantawat N, Waterfield NR et al (2009) PirAB toxin from Photorhabdus asymbiotica as a larvicide against dengue vectors. Appl Environ Microbiol 75:4627–4629
Audia JP, Winkler HH (2006) Study of the five Rickettsia prowazekii proteins annotated as ATP/ADP translocases (Tlc): only Tlc1 transports ATP/ADP, while Tlc4 and Tlc5 transport other ribonucleotides. J Bacteriol 188:6261–6268. doi:10.1128/JB.00371-06
Bent ZW, Poorey K, Brazel DM et al (2015) Transcriptomic analysis of Yersinia enterocolitica biovar 1B infecting murine macrophages reveals new mechanisms of extracellular and intracellular survival. Infect Immun 83:2672–2685. doi:10.1128/IAI.02922-14
Bleakley BH, Chen X (1999) Survival of insect pathogenic and human clinical isolates of Photorhabdus luminescens in previously sterile soil. Can J Microbiol 45:273–278. doi:10.1139/cjm-45-3-273
Bondi M, Messi P, Sabia C et al (1999) Antimicrobial properties and morphological characteristics of two Photorhabdus luminescens strains. New Microbiol 22:117–127
Bowen DJ, Ensign JC (1998) Purification and characterization of a high-molecular-weight insecticidal protein complex produced by the entomopathogenic bacterium Photorhabdus luminescens. Appl Environ Microbiol 64:3029–3035
Browne N, Heelan M, Kavanagh K (2013) An analysis of the structural and functional similarities of insect hemocytes and mammalian phagocytes. Virulence 4:597–603. doi:10.4161/viru.25906
Brugirard-Ricaud K, Duchaud E, Givaudan A et al (2005) Site-specific antiphagocytic function of the Photorhabdus luminescens type III secretion system during insect colonization. Cell Microbiol 7:363–371. doi:10.1111/j.1462-5822.2004.00466.x
Buchmann K (2014) Evolution of innate immunity: clues from invertebrates via fish to mammals. Front Immunol 5:1–8. doi:10.3389/fimmu.2014.00459
Calder PC, Yaqoob P (1999) Glutamine and the immune system. Amino Acids 17:227–241
Chitlaru T, Gat O, Gozlan Y et al (2006) Differential proteomic analysis of the Bacillus anthracis secretome: distinct plasmid and chromosome CO2-dependent cross talk mechanisms modulate extracellular proteolytic activities. J Bacteriol 188:3551–3571. doi:10.1128/JB.188.10.3551-3571.2006
Costa SCP, Girard PA, Brehélin M, Zumbihl R (2009) The emerging human pathogen Photorhabdus asymbiotica is a facultative intracellular bacterium and induces apoptosis of macrophage-like cells. Infect Immun 77:1022–1030. doi:10.1128/IAI.01064-08
Crane JK, Naeher TM, Broome JE, Boedeker EC (2013) Role of host xanthine oxidase in infection due to enteropathogenic and shiga-toxigenic Escherichia coli. Infect Immun 81:1129–1139. doi:10.1128/IAI.01124-12
Crawford JM, Portmann C, Zhang X et al (2012) Small molecule perimeter defense in entomopathogenic bacteria. Proc Natl Acad Sci 109:10821–10826. doi:10.1073/pnas.1201160109
Daborn PJ, Waterfield N, Blight M a, Ffrench-Constant RH (2001) Measuring virulence factor expression by the pathogenic bacterium Photorhabdus luminescens in culture and during insect infection. J Bacteriol 183:5834–5839. doi:10.1128/JB.183.20.5834-5839.2001
Daborn PJ, Waterfield N, Silva CP et al (2002) A single Photorhabdus gene, makes caterpillars floppy (mcf), allows Escherichia coli to persist within and kill insects. Proc Natl Acad Sci U S A 99:10742–10747. doi:10.1073/pnas.102068099
De Bruyne E, Ducatelle R, Foss D et al (2016) Oral glutathione supplementation drastically reduces Helicobacter-induced gastric pathologies. Sci Rep 6:20169. doi:10.1038/srep20169
Dowling AJ, Hodgson DJ (2014) An unbiased method for clustering bacterial effectors using host cellular phenotypes. Appl Environ Microbiol 80:1185–1196. doi:10.1128/AEM.03290-13
Dowling AJ, Daborn PJ, Waterfield NR et al (2004) The insecticidal toxin Makes caterpillars floppy (Mcf) promotes apoptosis in mammalian cells. Cell Microbiol 6:345–353. doi:10.1046/j.1462-5822.2003.00357.x
Duchaud E, Rusniok C, Frangeul L et al (2003) The genome sequence of the entomopathogenic bacterium Photorhabdus luminescens. Nat Biotechnol 21:1307–1313. doi:10.1038/nbt886
Eleftherianos I, Millichap PJ, ffrench-Constant RH, Reynolds SE (2006) RNAi suppression of recognition protein mediated immune responses in the tobacco hornworm Manduca sexta causes increased susceptibility to the insect pathogen Photorhabdus. Dev Comp Immunol 30:1099–1107. doi:10.1016/j.dci.2006.02.008
Fabbri A, Travaglione S, Fiorentini C (2010) Escherichia coli cytotoxic necrotizing factor 1 (CNF1): Toxin biology, in vivo applications and therapeutic potential. Toxins (Basel) 2:283–296. doi:10.3390/toxins2020282
Fan J, Ye J, Kamphorst JJ et al (2014) Quantitative flux analysis reveals folate-dependent NADPH production. Nature 510:298–302. doi:10.1038/nature13236
Farmer JJ, Jorgensen JH, Grimont PA et al (1989) Xenorhabdus luminescens (DNA hybridization group 5) from human clinical specimens. J Clin Microbiol 27:1594–1600
Felföldi G, Marokházi J, Képiró M, Venekei I (2009) Identification of natural target proteins indicates functions of a serralysin-type metalloprotease, PrtA, in anti-immune mechanisms. Appl Environ Microbiol 75:3120–3126. doi:10.1128/AEM.02271-08
Fischbach M a, Lin H, Liu DR, Walsh CT (2006) How pathogenic bacteria evade mammalian sabotage in the battle for iron. Nat Chem Biol 2:132–138. doi:10.1038/nchembio771
Fischer-Le Saux M, Viallard V, Brunel B et al (1999) Polyphasic classification of the genus Photorhabdus and proposal of new taxa: P. luminescens subsp. luminescens subsp. nov., P. luminescens subsp. akhurstii subsp. nov., P. luminescens subsp. laumondii subsp. nov., P. temperata sp. nov., P.temperata subsp. temperata subsp. nov. and P. asymbiotica sp. nov. Int J Syst Bacteriol 49(Pt 4):1645–1656. doi:10.1099/00207713-49-4-1645
Ganz T, Nemeth E (2015) Iron homeostasis in host defence and inflammation. Nat Rev Immunol 15:500–510. doi:10.1038/nri3863
Gatsogiannis C, Lang AE, Meusch D et al (2013) A syringe-like injection mechanism in Photorhabdus luminescens toxins. Nature 495:520–523. doi:10.1038/nature11987
Gerrard JG, Vohra R, Nimmo GR (2003) Identification of Photorhabdus asymbiotica in cases of human infection. Commun Dis Intell Q Rep 27:540–541
Gerrard J, Waterfield N, Vohra R, ffrench-Constant R (2004) Human infection with Photorhabdus asymbiotica: an emerging bacterial pathogen. Microbes Infect 6:229–237. doi:10.1016/j.micinf.2003.10.018
Gerrard JG, Joyce SA, Clarke DJ et al (2006) Nematode symbiont for Photorhabdus asymbiotica. Emerg Infect Dis 12:1562–1564. doi:10.3201/eid1210.060464
Gerrard JG, Waterfield NR, Sanchez-Contreeras M (2011) Photorhabdus asymbiotica: shedding light on a human pathogenic bioluminescent bacterium. Clin Microbiol Newsl 33:103–109. doi:10.1016/j.clinmicnews.2011.06.004
Godber BLJ, Doel JJ, Sapkota GP et al (2000) Reduction of nitrite to nitric oxide catalyzed by xanthine oxidoreductase. J Biol Chem 275:7757–7763. doi:10.1074/jbc.275.11.7757
Guijarro JA, Cascales D, García-Torrico AI et al (2015) Temperature-dependent expression of virulence genes in fish-pathogenic bacteria. Front Microbiol 6:1–11. doi:10.3389/fmicb.2015.00700
Hotez PJ, Brooker S, Bethony JM et al (2004) Hookworm Infection. N Engl J Med 351:799–807. doi:10.1056/NEJMra032492
Jank T, Bogdanović X, Wirth C et al (2013) A bacterial toxin catalyzing tyrosine glycosylation of Rho and deamidation of Gq and Gi proteins. Nat Struct Mol Biol 20:1273–1280. doi:10.1038/nsmb.2688
Joyce SA, Brachmann AO, Glazer I et al (2008) Bacterial biosynthesis of a multipotent stilbene. Angew Chemie—Int Ed 47:1942–1945. doi:10.1002/anie.200705148
Kimbrell DA, Beutler B (2001) The evolution and genetics of innate immunity. Nat Rev Genet 2:256–267. doi:10.1038/35066006
Kondakova AN, Kirsheva NA, Shashkov AS et al (2011) Low structural diversity of the O-polysaccharides of Photorhabdus asymbiotica subspp. asymbiotica and australis and their similarity to the O-polysaccharides of taxonomically remote bacteria including Francisella tularensis. Carbohydr Res 346:1951–1955. doi:10.1016/j.carres.2011.05.019
Konkel ME, Tilly K (2000) Temperature-regulated expression of bacterial virulence genes. Microbes Infect 2:157–166. doi:10.1016/S1286-4579(00)00272-0
Kuwata R, Yoshiga T, Yoshida M, Kondo E (2008) Mutualistic association of Photorhabdus asymbiotica with Japanese heterorhabditid entomopathogenic nematodes. Microbes Infect 10:734–741. doi:10.1016/j.micinf.2008.03.010
Lee C-T, Chen I-T, Yang Y-T et al (2015) The opportunistic marine pathogen Vibrio parahaemolyticus becomes virulent by acquiring a plasmid that expresses a deadly toxin. Proc Natl Acad Sci 112:10798–10803. doi:10.1073/pnas.1503129112
Letek M, González P, Macarthur I et al (2010) The genome of a pathogenic rhodococcus: cooptive virulence underpinned by key gene acquisitions. PLoS Genet. doi:10.1371/journal.pgen.1001145
Li J, Chen G, Wu H, Webster JM (1995) Identification of two pigments and a hydroxystilbene antibiotic from Photorhabdus luminescens. Appl Environ Microbiol 61:4329–4333
Liechti G, Goldberg JB (2012) Helicobacter pylori relies primarily on the purine salvage pathway for purine nucleotide biosynthesis. J Bacteriol 194:839–854. doi:10.1128/JB.05757-11
Mallo GV, Espina M, Smith AC et al (2008) SopB promotes phosphatidylinositol 3-phosphate formation on Salmonella vacuoles by recruiting Rab5 and Vps34. J Cell Biol 182:741–752. doi:10.1083/jcb.200804131
Martin HM, Hancock JT, Salisbury V, Harrison R (2004) Role of xanthine oxidoreductase as an antimicrobial agent. Infect Immun 72:4933–4939. doi:10.1128/IAI.72.9.4933-4939.2004
McLaughlin LM, Govoni GR, Gerke C et al (2009) The Salmonella SPI2 effector SseI mediates long-term systemic infection by modulating host cell migration. PLoS Pathog 5:e1000671. doi:10.1371/journal.ppat.1000671
Mulley G, Beeton ML, Wilkinson P et al (2015) From insect to man: Photorhabdus sheds light on the emergence of human pathogenicity. PLoS ONE 10:e0144937. doi:10.1371/journal.pone.0144937
Newsholme P, Procopio J, Ramos Lima MM et al (2003) Glutamine and glutamate—their central role in cell metabolism and function. Cell Biochem Funct 21:1–9. doi:10.1002/cbf.1003
Pankhaniya RR, Tamura M, Allmond LR et al (2004) Pseudomonas aeruginosa causes acute lung injury via the catalytic activity of the patatin-like phospholipase domain of ExoU. Crit Care Med 32:2293–2299
Park K-S, Ono T, Rokuda M et al (2004) Functional characterization of two type III secretion systems of Vibrio parahaemolyticus. Infect Immun 72:6659–6665. doi:10.1128/IAI.72.11.6659-6665.2004
Peat SM, Ffrench-Constant RH, Waterfield NR et al (2010) A robust phylogenetic framework for the bacterial genus Photorhabdus and its use in studying the evolution and maintenance of bioluminescence: a case for 16S, gyrB, and glnA. Mol Phylogenet Evol 57:728–740. doi:10.1016/j.ympev.2010.08.012
Plichta KL, Joyce SA, Clarke D et al (2009) Heterorhabditis gerrardi n. sp. (Nematoda: Heterorhabditidae): the hidden host of Photorhabdus asymbiotica (Enterobacteriaceae: gamma-Proteobacteria). J Helminthol 83:309–320. doi:10.1017/S0022149X09222942
Ren J, Prescott JF (2003) Analysis of virulence plasmid gene expression of intra-macrophage and in vitro grown Rhodococcus equi ATCC 33701. Vet Microbiol 94:167–182. doi:10.1016/S0378-1135(03)00099-3
Sato H, Frank DW, Hillard CJ et al (2003) The mechanism of action of the Pseudomonas aeruginosa-encoded type III cytotoxin, ExoU. EMBO J 22:2959–2969. doi:10.1093/emboj/cdg290
Schaible UE, Kaufmann SHE (2004) Iron and microbial infection. Nat Rev Microbiol 2:946–953. doi:10.1038/nrmicro1046
Shao F, Merritt PM, Bao Z et al (2002) A Yersinia effector and a Pseudomonas avirulence protein define a family of cysteine proteases functioning in bacterial pathogenesis. Cell 109:575–588. doi:10.1016/S0092-8674(02)00766-3
Shibayama K, Wachino JI, Arakawa Y et al (2007) Metabolism of glutamine and glutathione via γ-glutamyltranspeptidase and glutamate transport in Helicobacter pylori: possible significance in the pathophysiology of the organism. Mol Microbiol 64:396–406. doi:10.1111/j.1365-2958.2007.05661.x
Shikuma NJ, Pilhofer M, Weiss GL et al (2014) Marine tubeworm metamorphosis induced by arrays of bacterial phage tail-like structures. Science 343:529–533. doi:10.1126/science.1246794
Silva CP, Waterfield NR, Daborn PJ et al (2002) Bacterial infection of a model insect: Photorhabdus luminescens and Manduca sexta. Cell Microbiol 4:329–339. doi:10.1046/j.1462-5822.2002.00194.x
Stabb EV, Reich KA, Ruby EG (2001) Vibrio fischeri genes hvnA and hvnB encode secreted NAD+ -glycohydrolases. J Bacteriol 183:309–317. doi:10.1128/JB.183.1.309-317.2001
Sunanda BS (2009) Effect of temperature on the life cycle of entomopathogenic nematodes. J Biol Control, Steinernema Abbasi and Heterorhabditis Indica. doi:10.18641/jbc/23/2/46013
Thanwisai A, Tandhavanant S, Saiprom N et al (2012) Diversity of Xenorhabdus and Photorhabdus spp. and their symbiotic entomopathogenic nematodes from Thailand. PLoS One. doi:10.1371/journal.pone.0043835
Tjaden J, Winkler HH, Schwöppe C et al (1999) Two nucleotide transport proteins in Chlamydia trachomatis, one for net nucleoside triphosphate uptake and the other for transport of energy. J Bacteriol 181:1196–1202
Vlisidou I, Eleftherianos I, Dorus S et al (2010) The KdpD/KdpE two-component system of Photorhabdus asymbiotica promotes bacterial survival within M. sexta hemocytes. J Invertebr Pathol 105:352–362. doi:10.1016/j.jip.2010.09.020
Waterfield NR, Daborn PJ, Dowling AJ et al (2003) The insecticidal toxin Makes caterpillars floppy 2 (Mcf2) shows similarity to HrmA, an avirulence protein from a plant pathogen. FEMS Microbiol Lett 229:265–270. doi:10.1016/S0378-1097(03)00846-2
Waterfield N, Kamita SG, Hammock BD, Ffrench-Constant R (2005) The Photorhabdus Pir toxins are similar to a developmentally regulated insect protein but show no juvenile hormone esterase activity. FEMS Microbiol Lett 245:47–52. doi:10.1016/j.femsle.2005.02.018
Waterfield NR, Sanchez-Contreras M, Eleftherianos I et al (2008) Rapid virulence annotation (RVA): identification of virulence factors using a bacterial genome library and multiple invertebrate hosts. Proc Natl Acad Sci U S A 105:15967–15972. doi:10.1073/pnas.0711114105
Weissfeld AS, Halliday RJ, Simmons DE et al (2005) Photorhabdus asymbiotica, a pathogen emerging on two continents that proves that there is no substitute for a well-trained clinical microbiologist. J Clin Microbiol 43:4152–4155. doi:10.1128/JCM.43.8.4152-4155.2005
Wilkinson P, Waterfield NR, Crossman L et al (2009) Comparative genomics of the emerging human pathogen Photorhabdus asymbiotica with the insect pathogen Photorhabdus luminescens. BMC Genom 10:302. doi:10.1186/1471-2164-10-302
Wilkinson P, Paszkiewicz K, Moorhouse A et al (2010) New plasmids and putative virulence factors from the draft genome of an Australian clinical isolate of Photorhabdus asymbiotica. FEMS Microbiol Lett 309:136–143. doi:10.1111/j.1574-6968.2010.02030.x
Yang G, Dowling AJ, Gerike U et al (2006) Photorhabdus virulence cassettes confer injectable insecticidal activity against the wax moth. J Bacteriol 188:2254–2261. doi:10.1128/JB.188.6.2254-2261.2006
Zang Y-N, Jiang D-L, Cai L et al (2016) Use of a dose-response model to guide future clinical trial of benvitimod cream to treat mild and moderate psoriasis. Int J Clin Pharmacol Ther 54:87–95. doi:10.5414/CP202486
Zhu L, Liu X, Zheng X et al (2010) Global analysis of a plasmid-cured Shigella flexneri strain: new insights into the interaction between the chromosome and a virulence plasmid. J Proteome Res 9:843–854. doi:10.1021/pr9007514
Author information
Authors and Affiliations
Corresponding author
Editor information
Editors and Affiliations
Rights and permissions
Copyright information
© 2016 Springer International Publishing Switzerland
About this chapter
Cite this chapter
Hapeshi, A., Waterfield, N.R. (2016). Photorhabdus asymbiotica as an Insect and Human Pathogen. In: ffrench-Constant, R. (eds) The Molecular Biology of Photorhabdus Bacteria . Current Topics in Microbiology and Immunology, vol 402. Springer, Cham. https://doi.org/10.1007/82_2016_29
Download citation
DOI: https://doi.org/10.1007/82_2016_29
Published:
Publisher Name: Springer, Cham
Print ISBN: 978-3-319-52714-7
Online ISBN: 978-3-319-52715-4
eBook Packages: Biomedical and Life SciencesBiomedical and Life Sciences (R0)